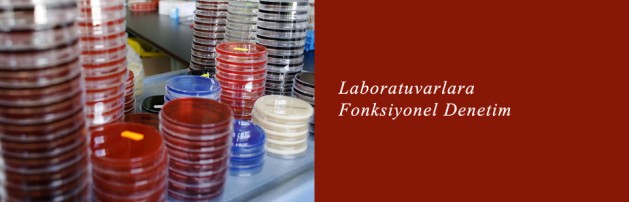

Laboratuvarlara fonksiyonel denetim
Sağlık Bakanlığı, hastadan örnek alma biçimi, koşulları, örnek aldığı kabın doğruluğu ve örneği inceleme süresi gibi kriterleri içine alan fonksiyonel denetimler yapacak.
AA | 01 EKİM 2013, 11:26
Kısa sürede, doğru ve güvenilir tanı koyabilmek için gerekli kimi tetkiklerin yapıldığı laboratuvarda mevcut yönetmeliği yenilemeye hazırlanan Sağlık Bakanlığı, fiziki koşullara uygunluk dışında hastadan örnek alma biçimi, koşulları, örnek aldığı kabın doğruluğu ve örneği inceleme süresi gibi kriterleri içine alan fonksiyonel denetimler yapacak.
Sağlık Bakanlığı Sağlık Hizmetleri Genel Müdürü İrfan Şencan, yaptığı açıklamada, sağlık hizmet sunumunda kalitenin artırılmasında, laboratuvarların çok önemli olduğunu söyledi.
Kısa sürede, doğru ve güvenilir tanı koyabilmek için gerekli tetkiklerin incelemesinin yapıldığı laboratuvarların önemine işaret eden Şencan, burada verilen hizmetin hata kabul etmediğini, yanlış tanı ve tedaviye uzanan, hatta hayati sonuçlara uzanabilen sonuçlara yol açabildiğini vurguladı.
Şencan, Bakanlık olarak hizmet sunumunda kalitenin artırılması için birçok alanda önemli adımlar attıklarını belirterek, “Bunun için laboratuvarlarla ilgili yeni bir yönetmelik taslağı hazırlıyoruz” dedi.
Mevcut yönetmelikte bazı eksikliklerin bulunduğunu dile getiren Şencan, süreç içerisinde eksiklerin kendini gösterdiğini ifade etti. Şencan, “Hizmet sunma şekli değişebiliyor, tetkiklere istenen ayrıntılar artabiliyor ve hatta yeni branşlar dahil olabiliyor. Bu nedenle, tüm bu ihtiyaçlara cevap verecek şekilde laboratuvar yönetmeliğini yeniliyoruz” diye konuştu.
Laboratuvarlarda hizmet kalitesi artırılıyor
Yeni yönetmelikle laboratuvarların fiziksel standartlarına ilişkin düzenlemelerin de bulunacağını anlatan Şencan, en önemli farklılıkların kalitesinin artırılmasına yönelik yapılacak değişikler olduğunu bildirdi.
Şencan, konuya ilişkin şunları söyledi:
“Laboratuvar hizmetinin prianalitik ayağında değişiklik yapılacak. Örneğin, kan şekeri bakılmadan önce, kanın hangi koşullarda alınması gerektiği, hastanın kaç saat öncesinden aç olması gerektiği, yorgunluk, gece gündüz uyku durumunun etkisi gibi faktörler dikkate alınacak.
İkinci olarak analitik süreçte, şekerin yükselme aşamasındaki basamaklara yapılanlar ve post analitik süreçte tetkike ilişkin bilginin hasta ve hekimine verilip verilmediğinden oluşuyor.
Şu anda hataların yüzde 60’ı prianalik, yüzde 15’i analitik ve yüzde 25-30’u da postanalitik süreçle ilgili. Yeni yönetmelikle, fonksiyonel denetim parametreleri getirilecek. Düzenlemede, laboratuvarın metrekaresinin uygunluğu ve teknik elemanı bulunup bulunmadığı gibi prensipler yine olacak, ancak şimdiye kadar ağırlıklı bu kriterlerden oluşuyordu. Şimdi ise süreçleri ortaya konulacak. Hastanın, örneği kabul edilirken yeterli inceleme yapılıp yapılmadığı, örneğin uygun olup olmadığı, örneğin alınma şatlarının ve alındığı kabın doğru olup olmadığı, örneğin bekleme ve incelenme süresi gibi kriterler belirlenecek. Buna göre, bir denetim oluşturulacak.”
Laboratuvarların dış kalite sonuçları izleniyor
Şencan, kamu, özel tüm laboratuvarların dış kalite kontrol sisteminden geçtiğini ifade ederek, “Dışarıdan, ilgili laboratuvara içeriği bilinen ancak merkezin bilmediği bir örnek gönderilir. Örnek test edilir ve dışarıdan gönderilen yere iletilir. Ölçülen sonucun, ideale ne kadar yakın olduğu belirlenir. Bunun için belli bir ücret ödenir. Şu anda bizim laboratuvarlarımızın hepsi bunu yaptırıyor” diye konuştu.
Buradan gelen sonuçların “çok dikkate alınmadığının” tespit edildiği eleştirisinde bulunan Şencan, şöyle devam etti:
“Örnek sonuçlar, kabul edilebilir sınırların dışına çıktığı halde, dikkate alınmamış olabiliyor. Hizmet alınıyor, ancak sonucu değerlendirilmiyor. Böyle bir süreç var. Şimdi, herkesin dış kalite kontrol sonuçlarını izlediğimiz bir sistem oluşturuldu. Yeni yönetmelikte bunun yaptırımlarını getiriyoruz.
Artık, fiziki ve personel şartları dışında fonksiyonel şartları takip eden bir düzenleme yapıldı. Bunu yerine getirmeyenler, belli puan aralıklarında önce uyarı, sonra yakın denetim yapılacak. Denetim sonrasında düzelme olmaması halinde o işle ilgili sorunlar düzeltilene kadar merkezin uygulama yapmasına izin verilmeyecek.”
“Aynı testten farklı merkezle farklı sonuçlar elde edilmesi önlenecek”
Şencan, farklı merkezlere yapılan aynı tetkike ilişkin sonuçlardaki uyuşmazlığın ciddi bir sorun olduğunun da altını çizdi.
Yapılacak olan düzenleme sonrasında sürece ilişkin denetimlerle bunun da önüne geçilebileceğini, kalitenin artırılacağını dile getiren Şencan, “Laboratuvarlarda örnek alma sürecini ve kriterlerini standardize ederek, aynı testten farklı merkezle farklı sonuçlar elde edilmesi önlenecek” diye konuştu.
Şencan, taslağın tamamlanmak üzere olduğunu sözlerine ekledi.